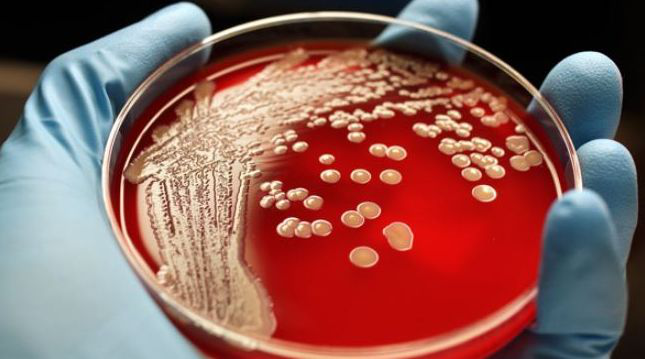
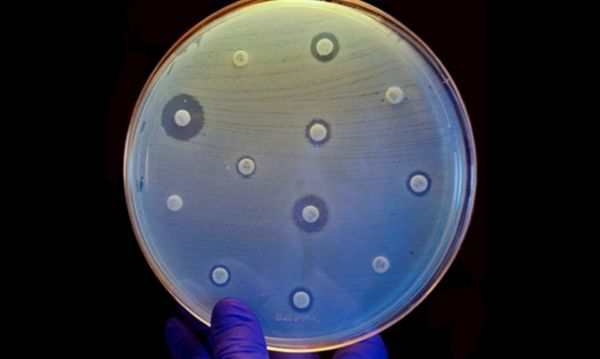

近些年来,细菌感染引发的耐药细菌性疾病不断发生,抗生素耐药性的现象已经频频出现,面对很多感染性疾病我们束手无策,而且患者也被迫在医院多呆一些时间进行治疗,预计截止到2050年,抗生素耐药性每年会引发一千万人死亡,而且还会引发全球GDP发生100万亿的损失。
近日有研究者报道,超级细菌在污水中不断进化,很有可能将将危及人们的饮食安全;同时来自南佛罗里达大学的研究者通过研究发现,耐药性细菌能够通过特殊的途径进入到人们日常的生活环境中,研究者发现,万古霉素耐药肠球菌(VRE)已经成为一种常见的院内获得性感染的原因,他们曾在圣彼德斯堡附近的水体和沉积物中已经发现了这种耐药性细菌。
因此,耐药性细菌对全球公共健康的威胁不容小觑,本文中,小编整理了近年来细菌耐药性的相关研究报道,与各位一起学习。

【1】PNAS:抵御耐药性细菌感染的重大突破
doi:10.1073/pnas.1510265112
金黄色葡萄球菌既是一种短暂的皮肤寄居者,也是一种可怕的人类病原体,主要可引发机体皮肤和软组织感染以及严重的肺炎;如今科学家们尝试了很多种策略来抵御这种病原体,然而大量的细菌都会对抗生素疗法产生耐受性,金黄色葡萄球菌的一种最重要的武器就是分泌α-毒素,这种毒素可以引发人类细胞破坏。
近日一项刊登在杂志PNAS上的研究论文中,来自斯坦福大学等处的科学家们通过研究鉴别出了调节细菌毒素毒力的细胞组分,尤其是这种名为PLEKHA7的蛋白质,通过消除这种蛋白的表达,细胞就会从α-毒素的伤害中恢复过来,缺失PLEKHA7蛋白的小鼠会送细菌感染中恢复过来,同时也会增强肺炎的生存率。
【2】Nature:科学家开发出一种不易致细菌产生耐药性的新型抗生素
doi:10.1038/nature14098
近日,刊登在国际著名杂志Nature上的一篇研究报告中,来自美国东北大学的研究人员利用一系列技术,成功分离出了一种名为teixobactin的新型抗菌化合物,研究者表示,teixobactin或许是一种新型的化合物,该化合物在小鼠机体中是有效且安全的,最关键的是其并不会诱发细菌耐药性的产生。
研究者Kim Lewis表示,小鼠是检测化合物毒性非常好的模式动物,对小鼠实验结果显示,新型化合物teixobactin可以有效清除小鼠机体中的细菌。Teixobactin可以特异性地结合革兰氏阳性菌细胞壁中高度保守的脂质,同时也会对细菌其它关键靶点实施攻击。
文章中,研究者在两种感染小鼠模型中进行了teixobactin的检测,一种为耐甲氧西林金黄色葡萄球菌血液感染的小鼠,另外一种为肺炎链球菌引发的肺部感染的小鼠模型;检测结果显示,化合物teixobactin可以有效治疗这两种小鼠的机体感染,而且使用的剂量对小鼠模型无任何副作用,更重要的是该化合物不会引发小鼠机体细菌产生耐药性。

【3】Nature:科学家或开发出抵御耐药细菌的新一代药物
doi:10.1038/nature17199
刊登在Nature上的一项报告中,东英吉利大学的科学家们距离解决抗生素耐药性问题又近了一步,他们揭示了耐药性细菌如何维持一种特殊的防御屏障来抵御抗生素的作用,该研究发现或帮助科学家们开发多种杀灭耐药性细菌的疗法,同时也可以帮助理解和机体多种障碍相关的人类细胞异常现象的发生,比如和糖尿病、帕金森疾病等。
本文研究受到威康信托基金会(The Wellcome Trust)支持,文章中研究人员主要对革兰氏阴性菌进行了研究,这类细菌对抗生素产生耐药性主要是因为细菌细胞存在不通透的外膜结构,而细菌外膜可以充当防御屏障来阻断人类机体免疫系统和抗生素药物的共计,从而使得病原菌存活,但移除该屏障就可以引发细菌对药物更加敏感。
【4】PNAS:中和耐药性细菌的新型蛋白质
doi:10.1073/pnas.1413271112
近年来,抗生素耐药性的感染率在逐年上升,超级细菌的流行给人们的健康带来了极大的威胁,近日,来自特拉维夫大学(Tel Aviv University)的研究人员通过研究鉴别出了一种可以中和抗生素耐药性细菌细胞的新型蛋白质,相关研究刊登于国际杂志PNAS上。
通过对病毒毒素产生耐药性的细菌DNA的测序,研究恩怨鉴别出了可以阻碍耐药性细菌生长的新型蛋白质;Qimron教授表示,由于细菌和细菌性病毒(噬菌体)共同进化了数亿年,因此我们猜测病毒或许包含有可以有效抵御细菌的武器,因此本文中我们对细菌性病毒的蛋白质进行了系统性地筛选。
利用高通量DNA测序技术,研究者对抵御细菌性病毒产生的毒性生长抑制剂有抗性的细菌进行了研究,确定了细菌细胞中的基因突变位点,随后研究者鉴别出了一种名为生长抑制基因产物0.6(Gp)的小型蛋白,其可以特殊性地靶向抑制对细菌细胞必须的蛋白质的活性。
【5】Cell Microbiol:抵御抗生素耐药性细菌的重大突破!
doi:10.1111/cmi.12573
近日,来自伊莱扎霍尔医学研究所等机构的研究人员通过研究发现,一种原本用来杀灭癌细胞的药物或可帮助抑制难以用普通抗生素治疗的感染性疾病,文章中研究人员利用成像技术实时观察可病原体(军团菌属细菌)如何感染机体免疫系统细胞。
2014年世界卫生组织就发布了第一份关于普通细菌对抗生素耐药性的报告,该报告呼吁抗生素耐药性已经成为目前影响全球公众健康的一个主要问题了。细菌通常会通过在病人机体细胞中“躲猫猫”来免于被抗生素杀灭,很多时候细菌会隐藏在巨噬细胞中,而巨噬细胞是一种可以程序性抵御细菌感染的机体免疫细胞。
研究抗生素耐药性细菌的很多研究都将目光聚焦于探索如何开发新型抗生素来抵御耐药细菌感染,研究者Naderer及其同事则通过观察揭示如何对病人机体的免疫系统进行重新装配来抑制机体对感染的敏感性。两种名为MCL-1和BCL-XL的蛋白质对于保持受感染巨噬细胞的活性非常关键,受感染的巨噬细胞会促进细菌生长并且发生扩散。
【6】AAC:细菌抗生素耐药性 挥之不去的社会问题
doi:10.1128/AAC.02441-15
近日,来自纽约大学的研究人员通过研究发现,微量浓度的抗生素或许都足以促进细胞产生抗生素耐药性,研究者表示,这种浓度低于此前他们预期的抗生素浓度,这或可帮助解释为何抗生素耐药性在环境中会持久存在。
抗生素耐药性可以以不同方式来发挥作用,文章中研究者描述了抗生素单一作用及共同作用时耐药性所表现出的不同机制;单一的药物耐受性或许可以使得单一细胞具有耐受性,而共同合作的抗生素耐药性或许使得耐药性细胞及其周围所有的细胞都表现出一定的耐受性。
文章中分析了大肠杆菌中一种名为RK2的质粒,RK2可以编码两种合作性的耐药性来抵御氨苄西林的作用,同时还可以编码一种利己的耐药性来抵御四环素的作用,研究者发现,这种利己耐药性可以在低于污水抗生素浓度100倍的时候被选择性地筛选出来。

【7】AAC:细菌耐药性产生远比预想的容易100倍,这是一个社会问题
原文报道:Antibiotic resistance: it's a social thing
纽约大学最新研究发现,微量浓度的抗生素,比如在排污口发现的,都足以使细菌产生耐药性。足以使细菌产生耐药的浓度比先前预期的要低很多,这有助于揭示为何环境中抗生素耐药是如此持续。
抗生素的抗性可以以不同的方式工作。研究中描述了抗性利己或合作式的不同机制。利己的药物抗性只对单个细胞有利,而合作式抗性对耐药细胞本身和耐药或非耐药的所有周围细胞都有利。
研究人员分析了在大肠杆菌中称为RK2的质粒——此细菌能引起传染性腹泻。RK2既编码对氨苄青霉素的合作式耐药性,也编码对四环素的利己抗性。他们发现利己药物耐受性比我们预想浓度低100倍使就能被选择出来——几乎与在受污染的排污口发现的抗生素残留的含量相同。
【8】PLoS Computational Biology:降低细菌耐药性方法的发现
doi:10.1016/j.celrep.2015.08.055
据估计,在美国每年有200万人感染细菌,这些细菌耐受一种或多种类型的抗生素,至少有23000人会死于这些感染。过度对牲畜过度使用抗生素会加剧这个问题的发生。这种过度使用抗生素再加上新型药物的缓慢发现对公众健康是一种日益严重的威胁。Moffitt癌症中心的研究人员受达尔文进化论的影响已经开发出一种新颖的数学方法使用当前抗生素来消除或减少耐药性细菌的发展。
根据疾病控制中心数据显示,抗击细菌耐药性感染主要方法是提高目前存在的抗生素使用量。实现这一目标的一个方法是通过使用不同的抗生素组合或序列;然而,由于抗生素的大量存在,将很难通过实验确定最佳药物组合或序列。
Moffitt研究人员开发了一种新颖的数学方法来分析抗生素耐药性从而克服了这一困难。他们显示大肠杆菌的耐药性可以促进或阻碍给定序列的抗生素。他们发现大约有70%不同序列的2到4种抗生素会导致最后的细菌耐药性。
【9】Sci Rep:电化学疗法有效治疗耐药性细菌感染
doi:10.1038/srep14908
近日,一项刊登于国际著名杂志Nature的子刊Scientific Reports上的研究报道中,来自华盛顿州立大学的研究人员通过研究首次揭示了电刺激如何治疗细菌感染,这就为后期开发治疗细菌感染的新型疗法提供希望。
文章中研究者用电流作用薄膜上的细菌,结果发现在24小时内电流几乎可以杀灭所有多重耐药的细菌,而这些细菌引发的感染如今非常难以治疗,所剩余存活的细菌仅为原始尺寸的1/10000。与此同时研究者还在猪机体的组织上进行了该实验,结果显示电刺激可以杀灭大部分细菌但对周围组织并无任何损伤影响。
一个多世纪以来,科学家们一直尝试利用电刺激来治疗感染的伤口,但所得到的结果往往不同,由于特定的原因,抗生素长期以来被认为是有限且最有效的治疗感染的疗法,但抗生素广泛的使用常常会引发细菌出现耐药性,在美国每年至少有200万感染及2.3万人死亡都归因于耐药性的细菌。
【10】Science:科学家发现对抗“超级细菌”的“超级英雄细菌”
原文报道:'Superhero' microbiome bacteria protect against deadly symptoms during infection
随着人们对耐抗生素的"超级细菌"关注度逐渐提升,Salk研究所的科学家们也许找到了能够解决这一难题的办法——即肠道部位寄生的、有时会移动到其它器官组织的"超级英雄"细菌。这些细菌能够减轻感染带来的长期负面效应。
在最近一期发表在《science》杂志上的一篇报告类文章中,salk研究所的研究人员发现小鼠微生物组中的一类大肠杆菌能够提高小鼠对肺部以及肠道感染的耐受性,具体体现在一般小鼠在受到感染时肌肉组织会出现消解,这一类细菌能够有效阻止这种情况的发生。如果人类体内能够找到具有相似特征的细菌,我们就有办法治疗由抗生素耐受性细菌引发的感染类疾病,比如脓毒症等。
"一直以来,我们对于治疗微生物感染的方案都集中在消除这些微生物上,然而真正具有致命性的并不是微生物感染本身,而是感染进一步引发的副效应。"该研究的主要作者,来自salk研究所的助理教授Janelle Ayres说到。
"我们的研究证明,对于一些损伤的阻止,比如肌肉消解症状,能够明显延缓感染造成的长期性危险"。如果我们不对这些细菌赶尽杀绝,它们也不会快速地进化从而变成我们都无能为力的超级细菌。

【11】Nature:粘菌素耐药基因将终结抗生素历史?非也!
原文报道:Spread of antibiotic-resistance gene does not spell bacterial apocalypse — yet
2015年11月,《柳叶刀.传染病》杂志上曾刊出爆炸性消息:来自中国的研究团队在动物和人身体细菌样本中均发现了一种新型耐药基因:粘菌素耐药基因(MCR-1基因)。这种抗药性可通过质粒,在细菌之间轻易地转移,目前在丹麦、 荷兰、法国及泰国均已检出该耐药基因。
粘菌素,属于多粘菌素类抗生素,由于具有肾毒性,其临床应用受到很大限制,目前主要在农业中广泛使用。据统计,中国每年农业畜牧生产中大约消耗12000吨粘菌素。
因此长期以来,相较于其他抗生素耐药性进展而言,粘菌素临床耐药性发展缓慢,主要表现为以土壤细菌耐药情况为主。而如今在人体及动物身上细菌样本中屡屡检出该耐药基因,十足令人震惊。
来源:生物谷
链接: //news.bioon.com/article/6690435.html


![]() 蜀ICP备10000600号
蜀ICP备10000600号

